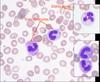

white blood cell Flashcards
(10 cards)
leucoerythroblastic
blood picture
In immune-mediated haemolytic anaemia (IMHA), a marked neutrophilia with a left shift is common. This is thought to be due to non-specific effects of marrow hyperactivity in response to the anaemia, endogenous steroid production and systemic inflammatory response secondary to tissue hypoxia and thrombosis. If the left shift is profound and accompanied by a strongly regenerative anaemia with circulating nucleated red blood cells (normoblastosis)
toxic change
morphological abnormalities seen in neutrophils
>>只能代表demand增加
注意:須為系統性,而非localized,像是在膀胱炎的膀胱觀察到類似變化就不算,但衍伸為腎臟炎的時候就能算是toxic change
常見於嚴重發炎反應,特別是嚴重的細菌感染,和IMHA(Immune Mediated Hemolytic Anemia,由藥物或中毒所致的免疫媒介溶血性貧血)。可以在neutrophil觀察到:
細胞質的嗜鹼性(cytoplasmic basophilia)增加,因為neutrophil吞噬了很多還不夠成熟的白血球,導致細胞質中的RNA殘骸增加(increased residual cytoplasmic RNA),並非吃了病原而留下的inclusion body
細胞質空泡化(cytoplasmic vacuolation):因成熟過程被干擾,導致顆粒缺少,及膜的完整性下降
Döhle bodies:為cytoplasmic reticulum聚集所造成的藍灰色質內包涵體,是為了要趕緊製造出較多的neutrophil所留下的殘餘物。在正常的貓中常見,因此必須要觀察到非常大量才能作為診斷依據,但狗中只要看到Döhle bodies就表示有toxic change。
Toxic granulation:因為酸性黏多醣 (acid mucopolysaccharides) 殘留在primary granule形成。可以在neutrophil觀察到:
Giant neutrophil:因為才在分裂前期就被派出來,沒有分裂到最後八分裂的小尺寸,所以neutrophil會比較大顆
Nuclear swelling:有band的狀況
Doughnut (ring) nuclei:甜甜圈樣的核,為band的一種。出現在嚴重全身性炎症反應或毒血症 (toxemia),在貓偶爾有,狗則罕見。
G
M
T
Y
检测语言世界语中文简体中文繁体丹麦语乌克兰语乌兹别克语乌尔都语亚美尼亚语伊博语俄语保加利亚语信德语修纳语僧伽罗语克罗地亚语冰岛语加利西亚语加泰罗尼亚语匈牙利语南非祖鲁语卡纳达语卢森堡语印地语印尼巽他语印尼爪哇语印尼语古吉拉特语吉尔吉斯语哈萨克语土耳其语塔吉克语塞尔维亚语塞索托语夏威夷语威尔士语孟加拉语宿务语尼泊尔语巴斯克语布尔语(南非荷兰语)希伯来语希腊语库尔德语弗里西语德语意大利语意第绪语拉丁语拉脱维亚语挪威语捷克语斯洛伐克语斯洛文尼亚语斯瓦希里语旁遮普语日语普什图语格鲁吉亚语毛利语法语波兰语波斯尼亚语波斯语泰卢固语泰米尔语泰语海地克里奥尔语爱尔兰语爱沙尼亚语瑞典语白俄罗斯语科萨科西嘉语立陶宛语索马里语约鲁巴语缅甸语罗马尼亚语老挝语芬兰语苏格兰盖尔语苗语英语荷兰语菲律宾语萨摩亚语葡萄牙语蒙古语西班牙语豪萨语越南语阿塞拜疆语阿姆哈拉语阿尔巴尼亚语阿拉伯语韩语马其顿语马尔加什语马拉地语马拉雅拉姆语马来语马耳他语高棉语齐切瓦语
世界语中文简体中文繁体丹麦语乌克兰语乌兹别克语乌尔都语亚美尼亚语伊博语俄语保加利亚语信德语修纳语僧伽罗语克罗地亚语冰岛语加利西亚语加泰罗尼亚语匈牙利语南非祖鲁语卡纳达语卢森堡语印地语印尼巽他语印尼爪哇语印尼语古吉拉特语吉尔吉斯语哈萨克语土耳其语塔吉克语塞尔维亚语塞索托语夏威夷语威尔士语孟加拉语宿务语尼泊尔语巴斯克语布尔语(南非荷兰语)希伯来语希腊语库尔德语弗里西语德语意大利语意第绪语拉丁语拉脱维亚语挪威语捷克语斯洛伐克语斯洛文尼亚语斯瓦希里语旁遮普语日语普什图语格鲁吉亚语毛利语法语波兰语波斯尼亚语波斯语泰卢固语泰米尔语泰语海地克里奥尔语爱尔兰语爱沙尼亚语瑞典语白俄罗斯语科萨科西嘉语立陶宛语索马里语约鲁巴语缅甸语罗马尼亚语老挝语芬兰语苏格兰盖尔语苗语英语荷兰语菲律宾语萨摩亚语葡萄牙语蒙古语西班牙语豪萨语越南语阿塞拜疆语阿姆哈拉语阿尔巴尼亚语阿拉伯语韩语马其顿语马尔加什语马拉地语马拉雅拉姆语马来语马耳他语高棉语齐切瓦语
文本转语音功能仅限200个字符
选项 : 历史 : 反馈 : Donate关闭
Chédiak-Higashi syndrome
先天性白細胞顆粒異常症候群
- Autosomal recessive disorder 體染色體隱性遺傳疾病
- causing Neutropenia 嗜中性球缺乏症
- 少見的隱性遺傳性疾病,一開始在Persian cat發現,但其他動物跟人類也會有,連albino orca(虎鯨)都有。
因為microtubule polymerization異常,使吞噬作用減少,導致動物容易受到感染,特別是Staphylococcus aureus(金黃色葡萄球菌)或Streptococci.(鏈球菌)。
一種灰毛牧羊犬特有的隱性體染色體遺傳疾病,為骨髓幹細胞異常所致。
人類也可能有,長大會復原
*老師說台灣collies不多,可以高興自己看:)
G
M
T
Y
检测语言世界语中文简体中文繁体丹麦语乌克兰语乌兹别克语乌尔都语亚美尼亚语伊博语俄语保加利亚语信德语修纳语僧伽罗语克罗地亚语冰岛语加利西亚语加泰罗尼亚语匈牙利语南非祖鲁语卡纳达语卢森堡语印地语印尼巽他语印尼爪哇语印尼语古吉拉特语吉尔吉斯语哈萨克语土耳其语塔吉克语塞尔维亚语塞索托语夏威夷语威尔士语孟加拉语宿务语尼泊尔语巴斯克语布尔语(南非荷兰语)希伯来语希腊语库尔德语弗里西语德语意大利语意第绪语拉丁语拉脱维亚语挪威语捷克语斯洛伐克语斯洛文尼亚语斯瓦希里语旁遮普语日语普什图语格鲁吉亚语毛利语法语波兰语波斯尼亚语波斯语泰卢固语泰米尔语泰语海地克里奥尔语爱尔兰语爱沙尼亚语瑞典语白俄罗斯语科萨科西嘉语立陶宛语索马里语约鲁巴语缅甸语罗马尼亚语老挝语芬兰语苏格兰盖尔语苗语英语荷兰语菲律宾语萨摩亚语葡萄牙语蒙古语西班牙语豪萨语越南语阿塞拜疆语阿姆哈拉语阿尔巴尼亚语阿拉伯语韩语马其顿语马尔加什语马拉地语马拉雅拉姆语马来语马耳他语高棉语齐切瓦语
世界语中文简体中文繁体丹麦语乌克兰语乌兹别克语乌尔都语亚美尼亚语伊博语俄语保加利亚语信德语修纳语僧伽罗语克罗地亚语冰岛语加利西亚语加泰罗尼亚语匈牙利语南非祖鲁语卡纳达语卢森堡语印地语印尼巽他语印尼爪哇语印尼语古吉拉特语吉尔吉斯语哈萨克语土耳其语塔吉克语塞尔维亚语塞索托语夏威夷语威尔士语孟加拉语宿务语尼泊尔语巴斯克语布尔语(南非荷兰语)希伯来语希腊语库尔德语弗里西语德语意大利语意第绪语拉丁语拉脱维亚语挪威语捷克语斯洛伐克语斯洛文尼亚语斯瓦希里语旁遮普语日语普什图语格鲁吉亚语毛利语法语波兰语波斯尼亚语波斯语泰卢固语泰米尔语泰语海地克里奥尔语爱尔兰语爱沙尼亚语瑞典语白俄罗斯语科萨科西嘉语立陶宛语索马里语约鲁巴语缅甸语罗马尼亚语老挝语芬兰语苏格兰盖尔语苗语英语荷兰语菲律宾语萨摩亚语葡萄牙语蒙古语西班牙语豪萨语越南语阿塞拜疆语阿姆哈拉语阿尔巴尼亚语阿拉伯语韩语马其顿语马尔加什语马拉地语马拉雅拉姆语马来语马耳他语高棉语齐切瓦语
文本转语音功能仅限200个字符
选项 : 历史 : 反馈 : Donate 关闭
检测语言世界语中文简体中文繁体丹麦语乌克兰语乌兹别克语乌尔都语亚美尼亚语伊博语俄语保加利亚语信德语修纳语僧伽罗语克罗地亚语冰岛语加利西亚语加泰罗尼亚语匈牙利语南非祖鲁语卡纳达语卢森堡语印地语印尼巽他语印尼爪哇语印尼语古吉拉特语吉尔吉斯语哈萨克语土耳其语塔吉克语塞尔维亚语塞索托语夏威夷语威尔士语孟加拉语宿务语尼泊尔语巴斯克语布尔语(南非荷兰语)希伯来语希腊语库尔德语弗里西语德语意大利语意第绪语拉丁语拉脱维亚语挪威语捷克语斯洛伐克语斯洛文尼亚语斯瓦希里语旁遮普语日语普什图语格鲁吉亚语毛利语法语波兰语波斯尼亚语波斯语泰卢固语泰米尔语泰语海地克里奥尔语爱尔兰语爱沙尼亚语瑞典语白俄罗斯语科萨科西嘉语立陶宛语索马里语约鲁巴语缅甸语罗马尼亚语老挝语芬兰语苏格兰盖尔语苗语英语荷兰语菲律宾语萨摩亚语葡萄牙语蒙古语西班牙语豪萨语越南语阿塞拜疆语阿姆哈拉语阿尔巴尼亚语阿拉伯语韩语马其顿语马尔加什语马拉地语马拉雅拉姆语马来语马耳他语高棉语齐切瓦语
世界语中文简体中文繁体丹麦语乌克兰语乌兹别克语乌尔都语亚美尼亚语伊博语俄语保加利亚语信德语修纳语僧伽罗语克罗地亚语冰岛语加利西亚语加泰罗尼亚语匈牙利语南非祖鲁语卡纳达语卢森堡语印地语印尼巽他语印尼爪哇语印尼语古吉拉特语吉尔吉斯语哈萨克语土耳其语塔吉克语塞尔维亚语塞索托语夏威夷语威尔士语孟加拉语宿务语尼泊尔语巴斯克语布尔语(南非荷兰语)希伯来语希腊语库尔德语弗里西语德语意大利语意第绪语拉丁语拉脱维亚语挪威语捷克语斯洛伐克语斯洛文尼亚语斯瓦希里语旁遮普语日语普什图语格鲁吉亚语毛利语法语波兰语波斯尼亚语波斯语泰卢固语泰米尔语泰语海地克里奥尔语爱尔兰语爱沙尼亚语瑞典语白俄罗斯语科萨科西嘉语立陶宛语索马里语约鲁巴语缅甸语罗马尼亚语老挝语芬兰语苏格兰盖尔语苗语英语荷兰语菲律宾语萨摩亚语葡萄牙语蒙古语西班牙语豪萨语越南语阿塞拜疆语阿姆哈拉语阿尔巴尼亚语阿拉伯语韩语马其顿语马尔加什语马拉地语马拉雅拉姆语马来语马耳他语高棉语齐切瓦语
文本转语音功能仅限200个字符
选项 : 历史 : 反馈 : Donate关闭
Döhle bodies
為cytoplasmic reticulum聚集所造成的藍灰色質內包涵體,是為了要趕緊製造出較多的neutrophil所留下的殘餘物。在正常的貓中常見,因此必須要觀察到非常大量才能作為診斷依據,但狗中只要看到Döhle bodies就表示有toxic change
G
M
T
Y
检测语言世界语中文简体中文繁体丹麦语乌克兰语乌兹别克语乌尔都语亚美尼亚语伊博语俄语保加利亚语信德语修纳语僧伽罗语克罗地亚语冰岛语加利西亚语加泰罗尼亚语匈牙利语南非祖鲁语卡纳达语卢森堡语印地语印尼巽他语印尼爪哇语印尼语古吉拉特语吉尔吉斯语哈萨克语土耳其语塔吉克语塞尔维亚语塞索托语夏威夷语威尔士语孟加拉语宿务语尼泊尔语巴斯克语布尔语(南非荷兰语)希伯来语希腊语库尔德语弗里西语德语意大利语意第绪语拉丁语拉脱维亚语挪威语捷克语斯洛伐克语斯洛文尼亚语斯瓦希里语旁遮普语日语普什图语格鲁吉亚语毛利语法语波兰语波斯尼亚语波斯语泰卢固语泰米尔语泰语海地克里奥尔语爱尔兰语爱沙尼亚语瑞典语白俄罗斯语科萨科西嘉语立陶宛语索马里语约鲁巴语缅甸语罗马尼亚语老挝语芬兰语苏格兰盖尔语苗语英语荷兰语菲律宾语萨摩亚语葡萄牙语蒙古语西班牙语豪萨语越南语阿塞拜疆语阿姆哈拉语阿尔巴尼亚语阿拉伯语韩语马其顿语马尔加什语马拉地语马拉雅拉姆语马来语马耳他语高棉语齐切瓦语
世界语中文简体中文繁体丹麦语乌克兰语乌兹别克语乌尔都语亚美尼亚语伊博语俄语保加利亚语信德语修纳语僧伽罗语克罗地亚语冰岛语加利西亚语加泰罗尼亚语匈牙利语南非祖鲁语卡纳达语卢森堡语印地语印尼巽他语印尼爪哇语印尼语古吉拉特语吉尔吉斯语哈萨克语土耳其语塔吉克语塞尔维亚语塞索托语夏威夷语威尔士语孟加拉语宿务语尼泊尔语巴斯克语布尔语(南非荷兰语)希伯来语希腊语库尔德语弗里西语德语意大利语意第绪语拉丁语拉脱维亚语挪威语捷克语斯洛伐克语斯洛文尼亚语斯瓦希里语旁遮普语日语普什图语格鲁吉亚语毛利语法语波兰语波斯尼亚语波斯语泰卢固语泰米尔语泰语海地克里奥尔语爱尔兰语爱沙尼亚语瑞典语白俄罗斯语科萨科西嘉语立陶宛语索马里语约鲁巴语缅甸语罗马尼亚语老挝语芬兰语苏格兰盖尔语苗语英语荷兰语菲律宾语萨摩亚语葡萄牙语蒙古语西班牙语豪萨语越南语阿塞拜疆语阿姆哈拉语阿尔巴尼亚语阿拉伯语韩语马其顿语马尔加什语马拉地语马拉雅拉姆语马来语马耳他语高棉语齐切瓦语
文本转语音功能仅限200个字符
选项 : 历史 : 反馈 : Donate 关闭
检测语言世界语中文简体中文繁体丹麦语乌克兰语乌兹别克语乌尔都语亚美尼亚语伊博语俄语保加利亚语信德语修纳语僧伽罗语克罗地亚语冰岛语加利西亚语加泰罗尼亚语匈牙利语南非祖鲁语卡纳达语卢森堡语印地语印尼巽他语印尼爪哇语印尼语古吉拉特语吉尔吉斯语哈萨克语土耳其语塔吉克语塞尔维亚语塞索托语夏威夷语威尔士语孟加拉语宿务语尼泊尔语巴斯克语布尔语(南非荷兰语)希伯来语希腊语库尔德语弗里西语德语意大利语意第绪语拉丁语拉脱维亚语挪威语捷克语斯洛伐克语斯洛文尼亚语斯瓦希里语旁遮普语日语普什图语格鲁吉亚语毛利语法语波兰语波斯尼亚语波斯语泰卢固语泰米尔语泰语海地克里奥尔语爱尔兰语爱沙尼亚语瑞典语白俄罗斯语科萨科西嘉语立陶宛语索马里语约鲁巴语缅甸语罗马尼亚语老挝语芬兰语苏格兰盖尔语苗语英语荷兰语菲律宾语萨摩亚语葡萄牙语蒙古语西班牙语豪萨语越南语阿塞拜疆语阿姆哈拉语阿尔巴尼亚语阿拉伯语韩语马其顿语马尔加什语马拉地语马拉雅拉姆语马来语马耳他语高棉语齐切瓦语
世界语中文简体中文繁体丹麦语乌克兰语乌兹别克语乌尔都语亚美尼亚语伊博语俄语保加利亚语信德语修纳语僧伽罗语克罗地亚语冰岛语加利西亚语加泰罗尼亚语匈牙利语南非祖鲁语卡纳达语卢森堡语印地语印尼巽他语印尼爪哇语印尼语古吉拉特语吉尔吉斯语哈萨克语土耳其语塔吉克语塞尔维亚语塞索托语夏威夷语威尔士语孟加拉语宿务语尼泊尔语巴斯克语布尔语(南非荷兰语)希伯来语希腊语库尔德语弗里西语德语意大利语意第绪语拉丁语拉脱维亚语挪威语捷克语斯洛伐克语斯洛文尼亚语斯瓦希里语旁遮普语日语普什图语格鲁吉亚语毛利语法语波兰语波斯尼亚语波斯语泰卢固语泰米尔语泰语海地克里奥尔语爱尔兰语爱沙尼亚语瑞典语白俄罗斯语科萨科西嘉语立陶宛语索马里语约鲁巴语缅甸语罗马尼亚语老挝语芬兰语苏格兰盖尔语苗语英语荷兰语菲律宾语萨摩亚语葡萄牙语蒙古语西班牙语豪萨语越南语阿塞拜疆语阿姆哈拉语阿尔巴尼亚语阿拉伯语韩语马其顿语马尔加什语马拉地语马拉雅拉姆语马来语马耳他语高棉语齐切瓦语
文本转语音功能仅限200个字符
选项 : 历史 : 反馈 : Donate关闭
Degenerative changes退化性變化
因暴露在內毒素(endotoxin)下造成,相較於循環系統,更常發生在組織,如果在血液看到就離天國不遠矣。
在組織及fluid sample可觀察到
只有在菌血症(bacteremia)或敗血症(septicemia)中,才可能在循環裡觀察到,但也是很少見或很些微。
造成:
細胞核腫大nuclear swelling
染色質分開沒那麼密集chromatin dissociation
細胞核嗜酸性化(nuclear eosinophilia)
Hypersegmented neutrophil過度分葉
血液放在EDTA太久(artifact)
Neutrophil存在循環系統裡的時間太長ex.長期使用過多類固醇
後天性
B12或是葉酸(Folic acid)的缺乏
貓FeLV myelodysplasia(老師說在貓看到lymphopenia或neutropenia要驗FeLV喔)
遺傳性的maturation defect
貴賓犬的Macrocytosis

Idiosyncratic drug reactions
特異質反應
with neutropenia
*名詞解釋:病人對藥物的非典型反應,通常不會發生,如蠶豆症患者使用抗氧化藥物造成溶血性貧血。
G
M
T
Y
检测语言世界语中文简体中文繁体丹麦语乌克兰语乌兹别克语乌尔都语亚美尼亚语伊博语俄语保加利亚语信德语修纳语僧伽罗语克罗地亚语冰岛语加利西亚语加泰罗尼亚语匈牙利语南非祖鲁语卡纳达语卢森堡语印地语印尼巽他语印尼爪哇语印尼语古吉拉特语吉尔吉斯语哈萨克语土耳其语塔吉克语塞尔维亚语塞索托语夏威夷语威尔士语孟加拉语宿务语尼泊尔语巴斯克语布尔语(南非荷兰语)希伯来语希腊语库尔德语弗里西语德语意大利语意第绪语拉丁语拉脱维亚语挪威语捷克语斯洛伐克语斯洛文尼亚语斯瓦希里语旁遮普语日语普什图语格鲁吉亚语毛利语法语波兰语波斯尼亚语波斯语泰卢固语泰米尔语泰语海地克里奥尔语爱尔兰语爱沙尼亚语瑞典语白俄罗斯语科萨科西嘉语立陶宛语索马里语约鲁巴语缅甸语罗马尼亚语老挝语芬兰语苏格兰盖尔语苗语英语荷兰语菲律宾语萨摩亚语葡萄牙语蒙古语西班牙语豪萨语越南语阿塞拜疆语阿姆哈拉语阿尔巴尼亚语阿拉伯语韩语马其顿语马尔加什语马拉地语马拉雅拉姆语马来语马耳他语高棉语齐切瓦语
世界语中文简体中文繁体丹麦语乌克兰语乌兹别克语乌尔都语亚美尼亚语伊博语俄语保加利亚语信德语修纳语僧伽罗语克罗地亚语冰岛语加利西亚语加泰罗尼亚语匈牙利语南非祖鲁语卡纳达语卢森堡语印地语印尼巽他语印尼爪哇语印尼语古吉拉特语吉尔吉斯语哈萨克语土耳其语塔吉克语塞尔维亚语塞索托语夏威夷语威尔士语孟加拉语宿务语尼泊尔语巴斯克语布尔语(南非荷兰语)希伯来语希腊语库尔德语弗里西语德语意大利语意第绪语拉丁语拉脱维亚语挪威语捷克语斯洛伐克语斯洛文尼亚语斯瓦希里语旁遮普语日语普什图语格鲁吉亚语毛利语法语波兰语波斯尼亚语波斯语泰卢固语泰米尔语泰语海地克里奥尔语爱尔兰语爱沙尼亚语瑞典语白俄罗斯语科萨科西嘉语立陶宛语索马里语约鲁巴语缅甸语罗马尼亚语老挝语芬兰语苏格兰盖尔语苗语英语荷兰语菲律宾语萨摩亚语葡萄牙语蒙古语西班牙语豪萨语越南语阿塞拜疆语阿姆哈拉语阿尔巴尼亚语阿拉伯语韩语马其顿语马尔加什语马拉地语马拉雅拉姆语马来语马耳他语高棉语齐切瓦语
文本转语音功能仅限200个字符
选项 : 历史 : 反馈 : Donate关闭
- Estrogen雌激素(動情素):白血球、紅血球、血小板、骨髓的抑制,不管是自己身體產生或誤配注射治療都有作用,且治療劑量與中毒劑量很近。
- chloramphenicol氯黴素:原本使用在經濟動物,治療皮膚病,人類長期吃會導致bone marrow suppression,全球停產。
- cephalosporins頭孢菌素:不會長期使用跟chloramphenicol原因相同,但較少人出現症狀。
G
M
T
Y
检测语言世界语中文简体中文繁体丹麦语乌克兰语乌兹别克语乌尔都语亚美尼亚语伊博语俄语保加利亚语信德语修纳语僧伽罗语克罗地亚语冰岛语加利西亚语加泰罗尼亚语匈牙利语南非祖鲁语卡纳达语卢森堡语印地语印尼巽他语印尼爪哇语印尼语古吉拉特语吉尔吉斯语哈萨克语土耳其语塔吉克语塞尔维亚语塞索托语夏威夷语威尔士语孟加拉语宿务语尼泊尔语巴斯克语布尔语(南非荷兰语)希伯来语希腊语库尔德语弗里西语德语意大利语意第绪语拉丁语拉脱维亚语挪威语捷克语斯洛伐克语斯洛文尼亚语斯瓦希里语旁遮普语日语普什图语格鲁吉亚语毛利语法语波兰语波斯尼亚语波斯语泰卢固语泰米尔语泰语海地克里奥尔语爱尔兰语爱沙尼亚语瑞典语白俄罗斯语科萨科西嘉语立陶宛语索马里语约鲁巴语缅甸语罗马尼亚语老挝语芬兰语苏格兰盖尔语苗语英语荷兰语菲律宾语萨摩亚语葡萄牙语蒙古语西班牙语豪萨语越南语阿塞拜疆语阿姆哈拉语阿尔巴尼亚语阿拉伯语韩语马其顿语马尔加什语马拉地语马拉雅拉姆语马来语马耳他语高棉语齐切瓦语
世界语中文简体中文繁体丹麦语乌克兰语乌兹别克语乌尔都语亚美尼亚语伊博语俄语保加利亚语信德语修纳语僧伽罗语克罗地亚语冰岛语加利西亚语加泰罗尼亚语匈牙利语南非祖鲁语卡纳达语卢森堡语印地语印尼巽他语印尼爪哇语印尼语古吉拉特语吉尔吉斯语哈萨克语土耳其语塔吉克语塞尔维亚语塞索托语夏威夷语威尔士语孟加拉语宿务语尼泊尔语巴斯克语布尔语(南非荷兰语)希伯来语希腊语库尔德语弗里西语德语意大利语意第绪语拉丁语拉脱维亚语挪威语捷克语斯洛伐克语斯洛文尼亚语斯瓦希里语旁遮普语日语普什图语格鲁吉亚语毛利语法语波兰语波斯尼亚语波斯语泰卢固语泰米尔语泰语海地克里奥尔语爱尔兰语爱沙尼亚语瑞典语白俄罗斯语科萨科西嘉语立陶宛语索马里语约鲁巴语缅甸语罗马尼亚语老挝语芬兰语苏格兰盖尔语苗语英语荷兰语菲律宾语萨摩亚语葡萄牙语蒙古语西班牙语豪萨语越南语阿塞拜疆语阿姆哈拉语阿尔巴尼亚语阿拉伯语韩语马其顿语马尔加什语马拉地语马拉雅拉姆语马来语马耳他语高棉语齐切瓦语
文本转语音功能仅限200个字符
选项 : 历史 : 反馈 : Donate关闭
inclusions- canine distemper犬瘟熱
- cytoplasmic inclusion bodies
- homogenously stained
- pink browndish in clor
G
M
T
Y
检测语言世界语中文简体中文繁体丹麦语乌克兰语乌兹别克语乌尔都语亚美尼亚语伊博语俄语保加利亚语信德语修纳语僧伽罗语克罗地亚语冰岛语加利西亚语加泰罗尼亚语匈牙利语南非祖鲁语卡纳达语卢森堡语印地语印尼巽他语印尼爪哇语印尼语古吉拉特语吉尔吉斯语哈萨克语土耳其语塔吉克语塞尔维亚语塞索托语夏威夷语威尔士语孟加拉语宿务语尼泊尔语巴斯克语布尔语(南非荷兰语)希伯来语希腊语库尔德语弗里西语德语意大利语意第绪语拉丁语拉脱维亚语挪威语捷克语斯洛伐克语斯洛文尼亚语斯瓦希里语旁遮普语日语普什图语格鲁吉亚语毛利语法语波兰语波斯尼亚语波斯语泰卢固语泰米尔语泰语海地克里奥尔语爱尔兰语爱沙尼亚语瑞典语白俄罗斯语科萨科西嘉语立陶宛语索马里语约鲁巴语缅甸语罗马尼亚语老挝语芬兰语苏格兰盖尔语苗语英语荷兰语菲律宾语萨摩亚语葡萄牙语蒙古语西班牙语豪萨语越南语阿塞拜疆语阿姆哈拉语阿尔巴尼亚语阿拉伯语韩语马其顿语马尔加什语马拉地语马拉雅拉姆语马来语马耳他语高棉语齐切瓦语
世界语中文简体中文繁体丹麦语乌克兰语乌兹别克语乌尔都语亚美尼亚语伊博语俄语保加利亚语信德语修纳语僧伽罗语克罗地亚语冰岛语加利西亚语加泰罗尼亚语匈牙利语南非祖鲁语卡纳达语卢森堡语印地语印尼巽他语印尼爪哇语印尼语古吉拉特语吉尔吉斯语哈萨克语土耳其语塔吉克语塞尔维亚语塞索托语夏威夷语威尔士语孟加拉语宿务语尼泊尔语巴斯克语布尔语(南非荷兰语)希伯来语希腊语库尔德语弗里西语德语意大利语意第绪语拉丁语拉脱维亚语挪威语捷克语斯洛伐克语斯洛文尼亚语斯瓦希里语旁遮普语日语普什图语格鲁吉亚语毛利语法语波兰语波斯尼亚语波斯语泰卢固语泰米尔语泰语海地克里奥尔语爱尔兰语爱沙尼亚语瑞典语白俄罗斯语科萨科西嘉语立陶宛语索马里语约鲁巴语缅甸语罗马尼亚语老挝语芬兰语苏格兰盖尔语苗语英语荷兰语菲律宾语萨摩亚语葡萄牙语蒙古语西班牙语豪萨语越南语阿塞拜疆语阿姆哈拉语阿尔巴尼亚语阿拉伯语韩语马其顿语马尔加什语马拉地语马拉雅拉姆语马来语马耳他语高棉语齐切瓦语
文本转语音功能仅限200个字符
选项 : 历史 : 反馈 : Donate关闭

Ehrlichia canis (morula) 犬艾利希體症
morphology
可在monocytes觀察,因為染色後偏紫色又稱桑椹體(morula)。台灣沒有會出現在neutrophils中的立克次體(rickettsia)。Monocyte的細胞質原本是偏透明的,在細胞質中觀察到有一紫藍色物質(紅色圈圈內)就是Ehrlichia canis。

What is this

Hepatozoonosis犬肝簇蟲病
狗貓吃掉tick感染,為tick-born。外觀像一個capsule 在neutrophil 內,不會對neutrophil造成嚴重影響,目前也沒藥醫。老師覺得很美。
G
M
T
Y
检测语言世界语中文简体中文繁体丹麦语乌克兰语乌兹别克语乌尔都语亚美尼亚语伊博语俄语保加利亚语信德语修纳语僧伽罗语克罗地亚语冰岛语加利西亚语加泰罗尼亚语匈牙利语南非祖鲁语卡纳达语卢森堡语印地语印尼巽他语印尼爪哇语印尼语古吉拉特语吉尔吉斯语哈萨克语土耳其语塔吉克语塞尔维亚语塞索托语夏威夷语威尔士语孟加拉语宿务语尼泊尔语巴斯克语布尔语(南非荷兰语)希伯来语希腊语库尔德语弗里西语德语意大利语意第绪语拉丁语拉脱维亚语挪威语捷克语斯洛伐克语斯洛文尼亚语斯瓦希里语旁遮普语日语普什图语格鲁吉亚语毛利语法语波兰语波斯尼亚语波斯语泰卢固语泰米尔语泰语海地克里奥尔语爱尔兰语爱沙尼亚语瑞典语白俄罗斯语科萨科西嘉语立陶宛语索马里语约鲁巴语缅甸语罗马尼亚语老挝语芬兰语苏格兰盖尔语苗语英语荷兰语菲律宾语萨摩亚语葡萄牙语蒙古语西班牙语豪萨语越南语阿塞拜疆语阿姆哈拉语阿尔巴尼亚语阿拉伯语韩语马其顿语马尔加什语马拉地语马拉雅拉姆语马来语马耳他语高棉语齐切瓦语
世界语中文简体中文繁体丹麦语乌克兰语乌兹别克语乌尔都语亚美尼亚语伊博语俄语保加利亚语信德语修纳语僧伽罗语克罗地亚语冰岛语加利西亚语加泰罗尼亚语匈牙利语南非祖鲁语卡纳达语卢森堡语印地语印尼巽他语印尼爪哇语印尼语古吉拉特语吉尔吉斯语哈萨克语土耳其语塔吉克语塞尔维亚语塞索托语夏威夷语威尔士语孟加拉语宿务语尼泊尔语巴斯克语布尔语(南非荷兰语)希伯来语希腊语库尔德语弗里西语德语意大利语意第绪语拉丁语拉脱维亚语挪威语捷克语斯洛伐克语斯洛文尼亚语斯瓦希里语旁遮普语日语普什图语格鲁吉亚语毛利语法语波兰语波斯尼亚语波斯语泰卢固语泰米尔语泰语海地克里奥尔语爱尔兰语爱沙尼亚语瑞典语白俄罗斯语科萨科西嘉语立陶宛语索马里语约鲁巴语缅甸语罗马尼亚语老挝语芬兰语苏格兰盖尔语苗语英语荷兰语菲律宾语萨摩亚语葡萄牙语蒙古语西班牙语豪萨语越南语阿塞拜疆语阿姆哈拉语阿尔巴尼亚语阿拉伯语韩语马其顿语马尔加什语马拉地语马拉雅拉姆语马来语马耳他语高棉语齐切瓦语
文本转语音功能仅限200个字符
选项 : 历史 : 反馈 : Donate关闭